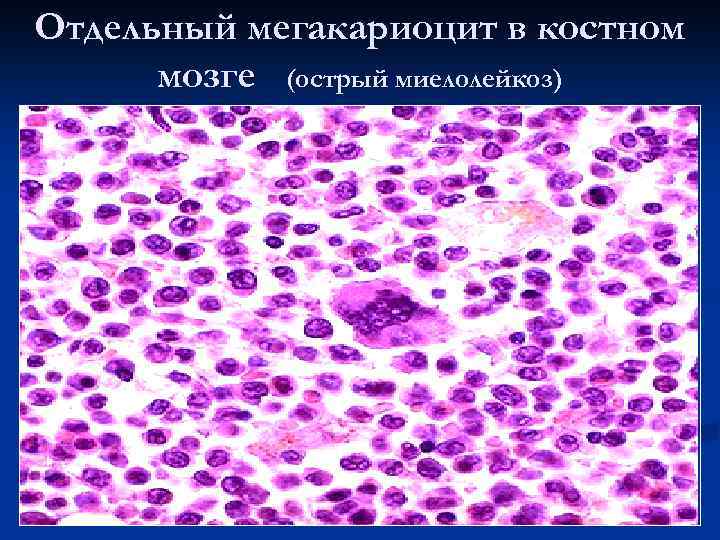

За что отвечает мегакариоцит
Ты не с кем кроме меня
Julia andrew
Мох под микроскопом с подписями
Размеры антенны на 145 мгц
Интел кор е5
Как правильно коптить мясо горячим копчением
Staff longer
Скрывается под максимом горьким
Теплоком 2аа
Путник гриб описание
Сош койгородок
Ovoz loyihasi final
Эсто садок омеловая
За что отвечает мегакариоцит 106 фото